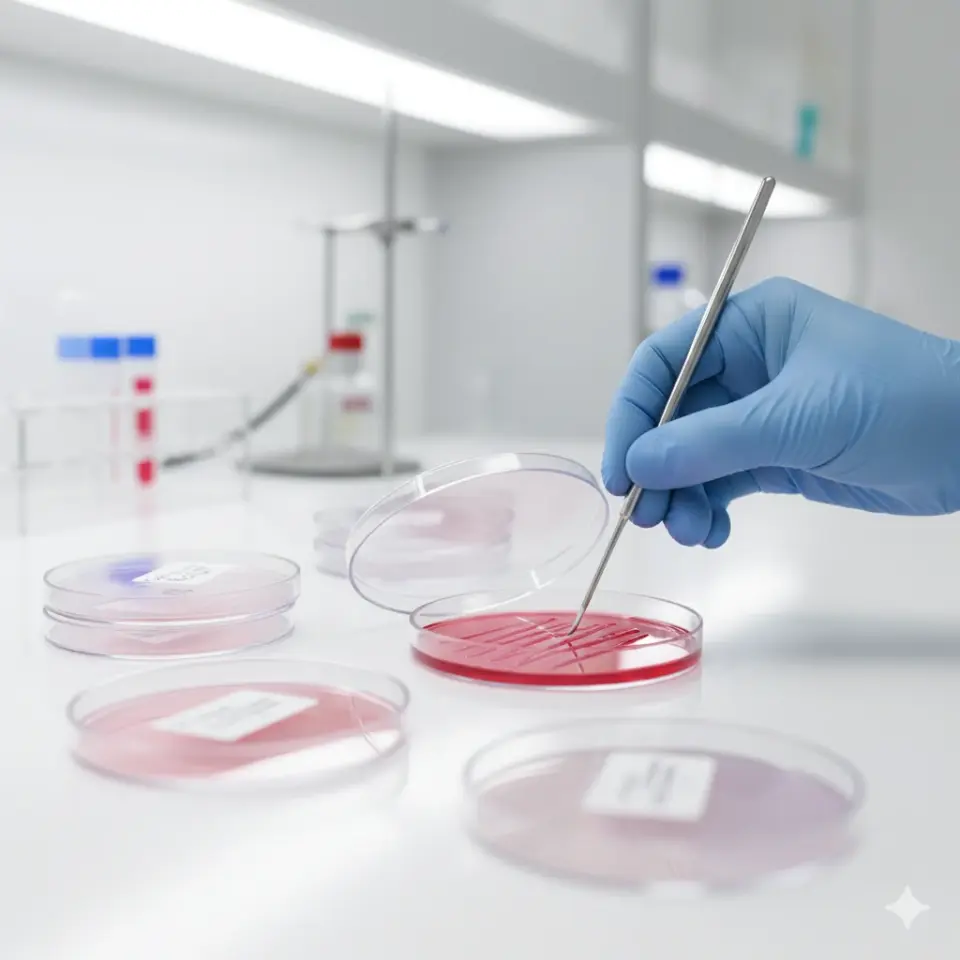
FIRATMED PETRİ KABI 90 MM STERİL 450 ADET/PK

FIRATMED PETRİ KABI 90 MM STERİL 450 ADET/PK
%30
2.310,00 TL
3.300,00 TL
Kategori
Marka
Stok Durumu
Var
Stok Kodu
8870000011
Fiyat
3.000,00 TL + KDV
*242,53 TL den başlayan taksitlerle!
Ürün Özellikleri
- Katalog Numarası: 8870000011
- Boyutlar: 90x15 mm
- Kalite: Yüksek kalite malzeme
- Saydamlık: Yüksek saydamlık özelliği
- Mukavemet: Yüksek mukavemete dayanıklı, kırılmazlık özelliği
- Uygunluk: Tüm doldurma dakinaları ile uyumlu
- Tasarım: Özel dizayn ile estetik ve fonksiyonel
- Sterilizasyon: Gamma sterilizasyon işlemi ile güvenli kullanım
Ürün Avantajları
FIRATMED PETRİ KABI, yüksek kalite ve dayanıklılık sunarak, profesyonel kullanıcıların ihtiyaçlarını karşılamak üzere tasarlanmıştır. 90 mm boyutları ve yüksek saydamlık özelliği, içeriğin görünürlüğünü artırırken, kırılmazlık özelliği ile güvenli bir kullanım sağlar. Tüm doldurma dakinaları ile uyumlu olması, kullanım alanını genişletir ve esneklik sunar. Gamma sterilizasyonu, hijyen standartlarını en üst düzeye çıkararak, güvenli bir deneyim sağlar.
Bu ürün, estetik ve fonksiyonel tasarımı ile laboratuvar ortamlarında ve diğer profesyonel alanlarda tercih edilmektedir. 8870000011 katalog numarasına sahip FIRATMED PETRİ KABI, yüksek kalite ve özel tasarımı ile sektördeki yerini sağlamlaştırmaktadır.
Bu ürüne ilk yorumu siz yapın!
Ürün hakkında henüz soru sorulmamış.
Sitemize ilk yorumu siz yapın!